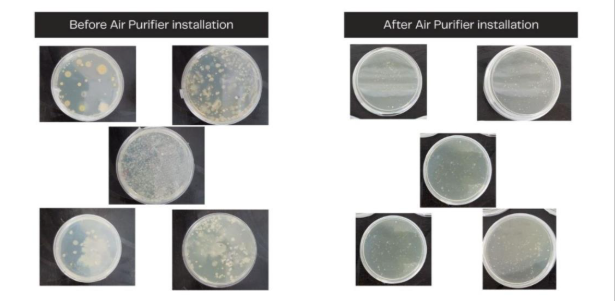

Clearing the Air: How Medical-Grade Filtration Improves Indoor Air Quality & Patient Safest 💨
Study Background

Multispeciality Hospital OMR in Perungudi, Chennai, is a high-density tertiary care centre serving critical and high-footfall patient zones. The hospital experienced particulate spikes (PM2.5/PM10), elevated formaldehyde levels, and CO₂ accumulation across several wards and critical care units, indicating stressed ventilation and indoor air challenges. During installation of the air-quality monitors and purifiers.
Figure: Deployed Air Quality Monitor (left) and Air Purifier (right) in the test location.
The Challenge: An Invisible Threat in a Critical Environment
A state-of-the-art tertiary care facility, Multispeciality Hospital, OMR, is committed to superior clinical outcomes. However, an initial IAQ assessment uncovered a silent crisis within its walls, with levels of key pollutants posing significant health risks:
Particulate Matter: PM2.5 levels (40–67 µg/m³) and PM10 (75–120 µg/m³) exceeded WHO and National Building Code limits, increasing respiratory distress risks for patients.
Harmful Chemicals: Formaldehyde, a volatile organic compound (VOC) from cleaning and building materials, averaged 200–900 ppb, far above the 100-ppb safety threshold, particularly in high-risk zones like the Emergency and NICU.
Poor Ventilation & Pathogens: CO₂ levels spiked to 1600 ppm in overcrowded areas like the OPD, indicating inadequate fresh air. Concurrently, high Total Bacterial and Yeast Counts (TBC/TYC) highlighted a tangible infection control risk.
The findings pointed to an urgent need for intervention to protect patient recovery, staff wellbeing, and the hospital's reputation for safety.
The Solution: A Strategic, Data-Driven Intervention
Multispeciality Hospital partnered with Medcuore to implement a precision-based air quality improvement strategy.
Precision Monitoring:
High-precision IoT sensors were deployed across 15 critical zones including ICUs, OTs, Dialysis, and Wards to collect baseline data on pollutants and microbes.
Targeted Deployment:
- Medical-grade air purifiers with True HEPA H13 filtration and high-absorption Activated Carbon were strategically installed.
- CADR (Clean Air Delivery Rate) capacities ranging from 400–850 m³/hr were selected based on zone size, patient load, and contamination levels to ensure optimal ACH (Air Changes per Hour).
Clear Objectives:
The pilot aimed for a minimum 50% reduction in PM2.5 and formaldehyde, an 80% reduction in pathogens, and a measurable improvement in CO₂ levels through enhanced clean air delivery.
Integration with HIS Framework: ️
Air quality improvements were benchmarked against our Health Index Score (HIS) model, evaluating comfort, pollutant load, and microbial safety.
Zones were prioritized based on HIS gaps to maximize patient-impact returns.
Figure: Air Purifier installation shows a clear reduction in microbial colonies.
The Implementation & Impact: Measurable Results
| Key Metric | Reduction Achieved | ISO Values | Outcome |
|---|---|---|---|
| PM2.5 | >67% | ≤ 25 µg/m³ | Full compliance with WHO/NBC standards |
| Formaldehyde | 83% | ≤ 100 ppb | Nearing full compliance; major risk reduction |
| Total Bacterial Count | 91% | ≤ 100–500 CFU/m³ | Significant infection control improvement |
| Total Yeast/Mould | 90% | ≤ 100–300 CFU/m³ | Reduced microbial risk in humid zones |
| Zone Compliance | — | ISO Class 8–6 | Achieved NABH standards in nearly all monitored areas |
Staff & Patient Feedback:
Our team personally collected feedback across the hospital from doctors to frontline staff, revealing that 85% reported improved comfort with reduced respiratory irritation, and 90% expressed overall satisfaction with the IAQ intervention.
Impact on HIS (Health Index Score):
HIS values improved by 28–45% across critical zones, reflecting cleaner air, better comfort, and lower microbial presence.

Figure: Air-quality parameter trends showing significant improvement post Air Purifier installation.
Operational Indices:
The proprietary Health, Productivity, and Energy Indices showed marked improvement, indicating a healthier, more efficient environment with reduced HVAC load due to improved CADR-supported recirculation efficiency.
Overcoming Challenges: A Path to Sustained Excellence
- CO₂ Management: Limited reduction (5%) highlighted the need for integrated ventilation upgrades beyond purification.
- Chemical Source Control: Persistent formaldehyde hotspots require a shift to low-VOC cleaning agents and improved housekeeping ventilation cycles.
Conclusion & Vision for the Future
The Mult-speciality Hospital, OMR pilot stands as a strong proof-of-concept. By integrating high-CADR medical-grade filtration with continuous monitoring and HIS-driven prioritization, the hospital has significantly reduced immediate health risks and enhanced patient safety.
